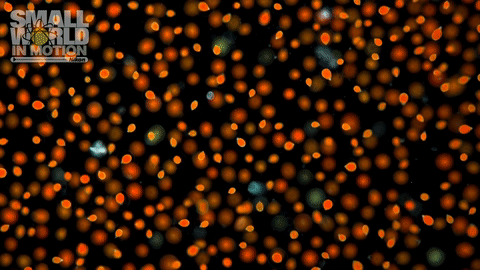
hm-gunther.gif

"Small World in Motion": Nikon contest winners
Nikon’s 2016 Small World in Motion digital video competition puts the spotlight on incredible microscopic moving images. The contest attracts entries from photographers and scientists all over the world.
William Gilpin, a Stanford Ph.D. student in physics, and his team won first place for this work, capturing “the complex and beautiful currents that a starfish larva creates around itself to capture food.”
Second place: Predatory ciliate
Charles Krebs, an experienced photomicrographer, took second place with this video of a Lacrymaria olor, or swan’s tear. This predatory ciliate is a group of protozoans characterized by their hair-like organelles called cilia.
“It illustrates the amazing diversity of life forms in the microscopic world,” Krebs said.
Third place: Flowering fungus
Dutch photographer Wim van Egmond captured the flowering of Aspergillus niger, a mold that typically grows on different types of fruit.
Zebrafish embryo
Dr. Philipp Keller, Kristin Branson, and Fernando Amat of the Howard Hughes Medical Institute in Virginia captured video of automated cell tracking in an entire developing zebrafish embryo.
Their work was one of 17 entries to receive an honorable mention from the Nikon contest judges.
Cell division
Micrasterias rotate cell division, by Wim van Egmond.
Crystal growth
Paracetamol crystal growth is seen in this video by Peter Juzak of the Sony Fotoclub in Hannover, Germany.
Purified proteins
Dr. Anthony Vecchiarelli and Dr. Kiyoshi Mizuuchi of the U.S. National Institutes of Health captured the self-organization of purified proteins important in bacterial cell division.
HaCaT cells
HaCaT cells expressing a fluorescent microtubule marker are seen in this video by Dr. Michael Weber of Harvard Medical School.
Attacking a cancer cell
In vitro visualization of natural killer cells attacking a cancer cell, by Tsutomu Tomita.
German wasp
Jan Rosenboom captured this 80x magnification of a German wasp (vespula germanica) awakening.
Rotifer with tentacles
An 80-times magnified image of Rotifer (Collotheca spec.) with tentacles, photographed by Frank Fox.
Tubeworm defecation
Aquatic (freshwater) tubeworm defecation is seen in this 100x magnification video by Ralph Grimm of Queensland, Australia.
Roundworm embryo
Dr. Liang Gao of Stony Brook University’s department of chemistry captured the developmental process of an early stage C. elegans embryo with individual cells rendered in different colors.
Faucet snail
This video by Dr. Robert Markus of the University of Nottingham in the U.K. shows the birth and first steps of a faucet snail.
Tadpole blood circulation
Blood circulation in the tail of a cane toad tadpole (Bufo Marinus), captured by Ralph Grimm.
Drosophila larva
Dr. Philipp Keller and Raghav K. Chhetri of the Howard Hughes Medical Institute in Virginia won an honorable mention for this spatially isotropic whole-animal functional imaging of a behaving Drosophila (fruit fly) larva labeled with a calcium indicator.
Zebrafish embryos
In this video by Dr. Elliott Hagedorn and Brian Li of Boston Children’s Hospital and Harvard Medical School, fluorescent dextran dye is injected into circulation, which subsequently illuminates the common blood flow between the parabiotic zebrafish embryos.
Living alga cells
Living alga cells Haematococcus found in a bird bath, photographed by Gerd Günther.
Cheese mites
Hundreds of harmless cheese mites (Tyrophagus casei) bustle across a rind of cheddar cheese, in this video by Dr. Scott Chimileski of Harvard Medical School.
Neuron connections
Neurons seeded in two different micro-compartments extend their neurites through micro-tunnels to establish connections with each other, in this video by Dr. Renaud Renault of the Institut Curie and Weizmann Institute in Paris.